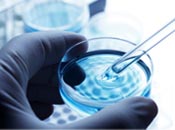
otras pruebas

Preparar el embarazo, ¿en qué puede ayudarme mi matrona?
Consultar antes de concebir reduce riesgos en la gestación
Quizá nunca te has planteado la importancia de preparar tus embarazos con meses de antelación.
Sin embargo, es un asunto de vital importancia para tu salud y especialmente para la salud de tu bebé. La consulta al médico de atención primaria, al ginecólogo o a la matrona puede darte muchas claves para lograr lo que estás buscando: un embarazo sano.
Planear el embarazo tiene ventajas
Cuando una pareja se plantea tener un hijo, puede ser muy útil hacer un cálculo de los días fértiles, pero lo es mucho más hacer una visita al médico o a la matrona. En la actualidad, esta recomendación, no se sigue de forma general, ya que la mayoría de las mujeres acude a la consulta cuando ya está embarazada. Conviene que sepas que el bienestar durante el embarazo depende en gran medida de tu estado de salud antes de la concepción. Por tanto sería deseable que consiguieras llegar al embarazo en las mejores condiciones físicas y psicológicas.
¿A qué mujeres les puede resultar útil esta consulta?
Su utilidad no solo se limita a las mujeres con alguna enfermedad previa o con embarazos anteriores complicados. También puede ser beneficiosa para todas las mujeres sanas en las que no se conocen factores de riesgo que puede afectar su reproducción.
¿Cuándo y para qué realizar esta visita preconcepcional?
La visita preconcepcional planificada, debería tener lugar en el intervalo de un año antes del embarazo.
Los objetivos de la consulta previa a la gestación son:
- Conocer tu estado de salud.
- Identificar posibles factores de riesgo, tuyos o de tu pareja, que pudieran afectar de forma negativa al embarazo.
- Recomendaros estilos y hábitos de vida saludables, como empezar a tomar suplementos de ácido fólico, y abandonar el tabaco o el alcohol.
- Con todo ello contribuir a que el embarazo se desarrolle de forma más saludable y segura.
¿Cómo es la visita preconcepcional con la matrona?
Historia médica
Te realizaran una entrevista para analizar tu historia familiar, personal y reproductiva. Si padeces alguna enfermedad como diabetes, hipertensión, disfunciones de la glándula tiroides o alteraciones cardiacas, conviene conseguir el mejor grado de compensación de la enfermedad, antes del embarazo. Si tomas medicación, en algunos casos el médico realizará ajustes y cambios farmacológicos, eligiendo los que han demostrado su inocuidad, ya que algunos medicamentos pueden tener efectos nocivos para el feto.
Analíticas
Probablemente se solicite una analítica general y de tu estado inmunitario. En relación con determinadas enfermedades infecciosas, como la toxoplasmosis, lo idóneo sería conocer el resultado analítico, antes de la gestación, por si hubiera que incidir en determinadas recomendaciones si hubiera riesgo de transmisión, como en esta infección sería no tomar determinados alimentos. Algunas conductas sexuales –como tener distintas parejas¬– aumentan el riesgo de contagio de enfermedades como la sífilis, gonorrea o infección por VIH.
Vacunas
Es importante revisar tu estado de vacunación: Las mujeres en edad fértil deben tener actualizadas las vacunas, en especial tétanos, hepatitis B, triple vírica (sarampión, paperas y la rubéola) Estas enfermedades si se adquieren durante el embarazo pueden resultar peligrosas para el feto en formación, pudiendo producir abortos y algunas malformaciones.
Alimentación
Se valorará tu estado nutricional. En caso de peso elevado, se te aconsejará, que lo pierdas antes de quedarte embarazada. Es recomendable que te alimentes de forma variada y equilibrada, ya que un buen estado nutricional en el momento de la concepción cubrirá mejor las necesidades que supone la gestación y va a contribuir a mejores resultados gestacionales. También es muy saludable practicar algo de ejercicio físico de forma regular.
Otras pruebas
En alguna ocasión puede ser necesaria vuestra derivación a consulta de genética, para completar la valoración con pruebas Se actualizará el control ginecológico, haciendo hincapié en la prevención del cáncer de cervix.